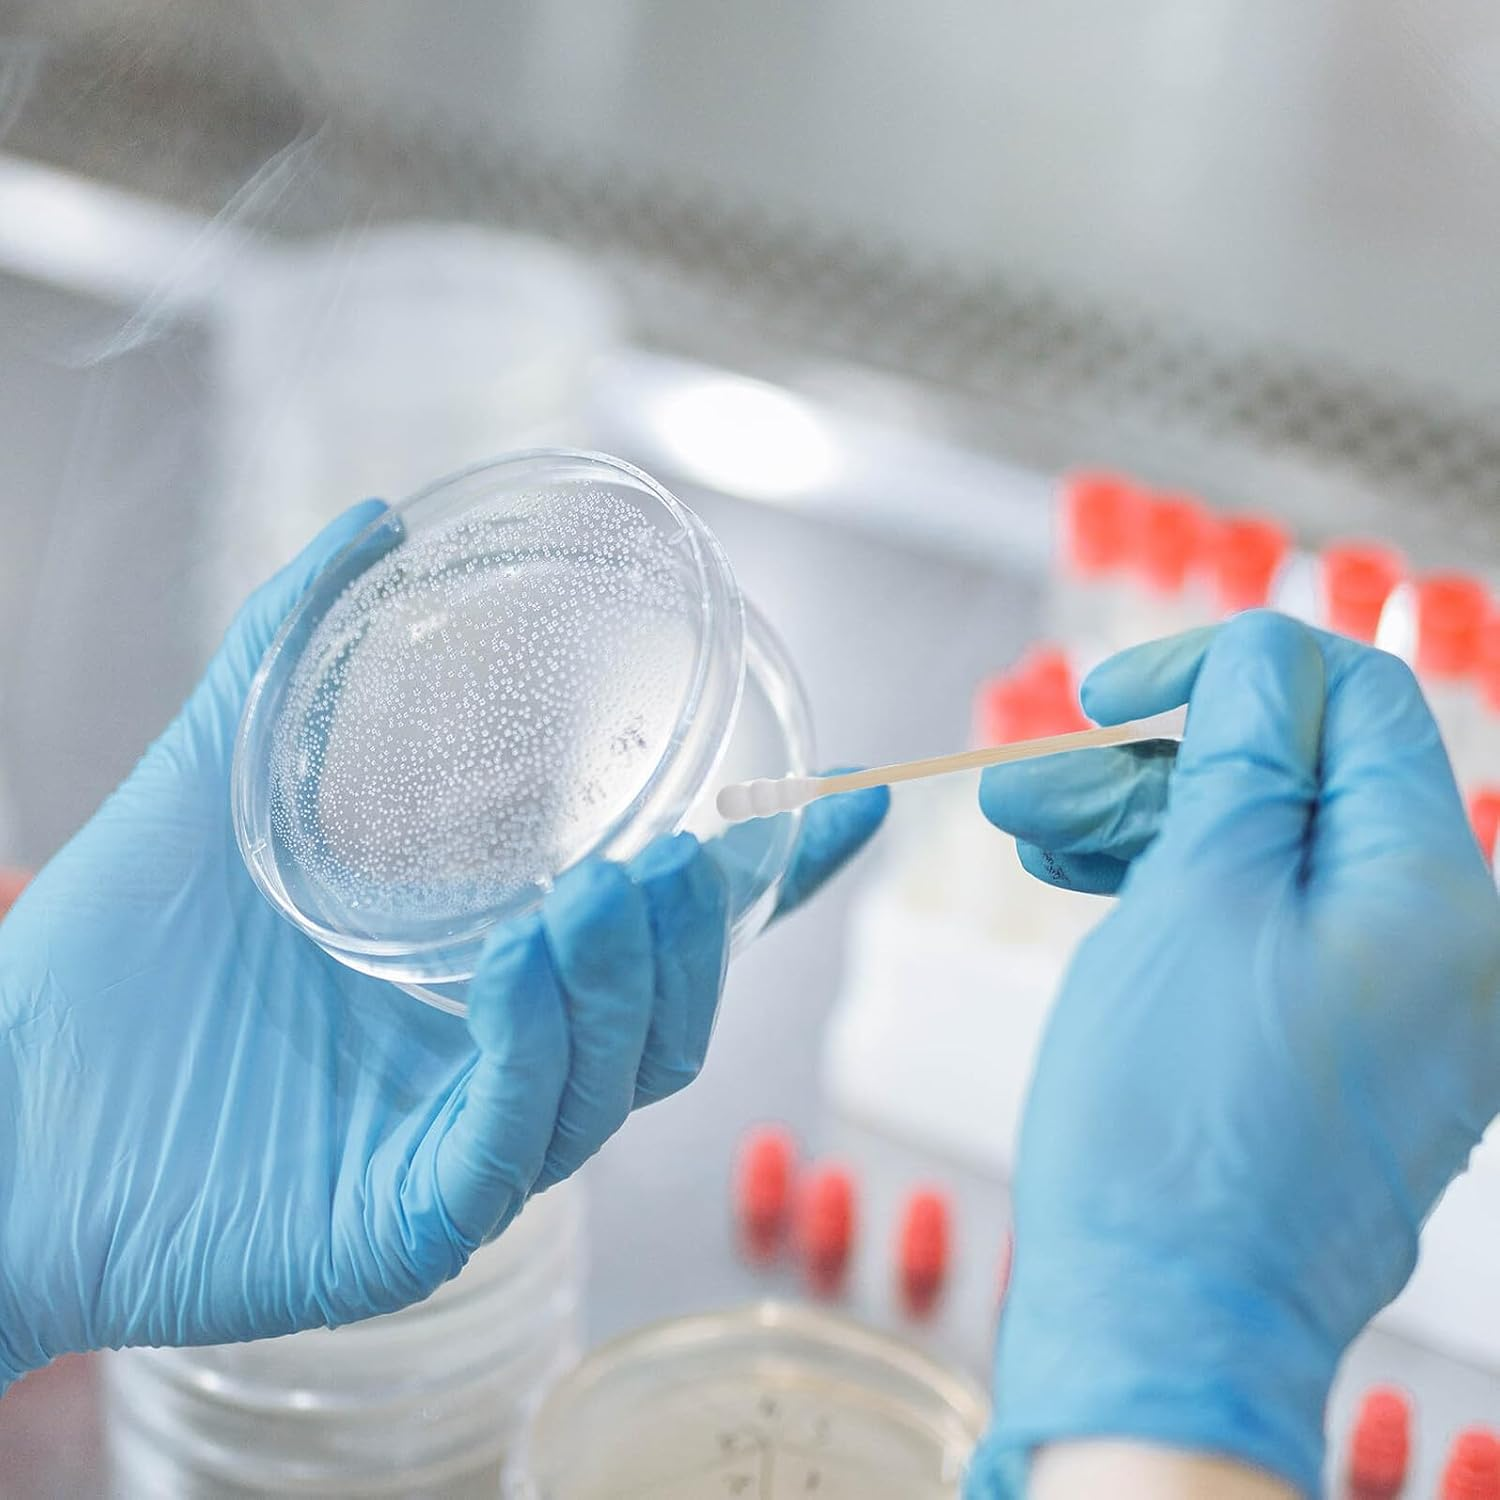
GANAZONO 500Pcs Dual-Ended Cotton Swabs with Wooden Stems for Ear Cleaning and Makeup Removal Soft round Cotton Tips for Cosmetic Use and Hygiene Lightweight Portable Health Care Essentials image number 3

GANAZONO 500Pcs Dual-Ended Cotton Swabs with Wooden Stems for Ear Cleaning and Makeup Removal Soft round Cotton Tips for Cosmetic Use and Hygiene Lightweight Portable Health Care Essentials


GANAZONO 500Pcs Dual-Ended Cotton Swabs with Wooden Stems for Ear Cleaning and Makeup Removal Soft round Cotton Tips for Cosmetic Use and Hygiene Lightweight Portable Health Care Essentials
-
This item is currently not available
Shop with confidence
- Versatile design: features a round cotton tip and a wooden stick for different cleaning and cosmetic needs,cosmetic cotton swab,gauze swabs
- Portable and lightweight: easy to carry, for travel and daily use,reusable ear swabs,piercing aftercare swabs
- Pure and safe: made from pure cotton and sanitized wooden sticks for maximum safety,cotton swabs for ears,computer cleaning wipes swabs
- friendly: soft cotton tips are for cleaning a ears,single use cotton swabs,cleaning swabs for electronics
- Versatile use: ideal for makeup removal, cosmetic application, beauty routines, and general cleaning,cleaning swabs for commercial uses,cotton swab for ear cleaning
Package Include
500Pcs x Cotton swab
Characteristics
- safe: soft and delicate cotton tips are for cleaning a ears nail polish cotton swab
-Material:Cotton,wood eyelash extension cleaning swab
-Size: 7.00X0.40X0.40cm/2.75X0.16X0.16in cotton swab for ear cleaning
-Safe and : made from pure cotton and wooden sticks, ensuring safety and reliability safety swabs for ears
-Color:Assorted Color travel cotton swabs
-Dual ended design: features a round cotton tip on one end and a wooden stick on the other, catering to various needs cleaning swabs for commercial uses
-Product Info:Cotton swab
-Portable: compact and lightweight, easy to carry and use anytime, anywhere eyeshadow cotton swab
-Versatile use: ideal for makeup removal, cosmetic application, beauty routines, and general cleaning cleaning swabs for electronics
Goods Description
cotton tip stick Whether you need to clean your ears, apply makeup, or perform beauty routines, these swabs are versatile and reliable.piercing aftercare swabs The soft cotton tips ensure gentle care for sensitive areas, providing a comfortable and effective cleaning experience.oil absorbing cotton swab Our dual-headed round cotton swabs are designed with a wooden stick, making them for a variety of uses
- Item Weight: 98.7 g
- Item Model Number: 24B40YH17ZCCA9W17CXTK5B
- Product dimensions: 7 x 0.4 x 0.4 cm; 98.7 Grams
- Country of origin: China
- Manufacturer: GANAZONO
-
This item is currently not available